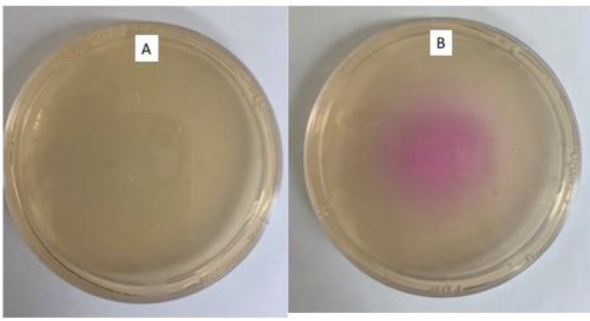
<p>B</p>

1/69
Looks like no tags are added yet.
Name | Mastery | Learn | Test | Matching | Spaced | Call with Kai |
|---|
No analytics yet
Send a link to your students to track their progress
What are 3 general products that you get from different fermentations?
acid (phenol red)
alcohol (gas bubbles and no acid production)
gas (Durham tube - trap gas bubbles)

A
Negative (red broth/no gas in the Durham tube)

C
Positive (red broth/gas in the Durham tube)

B
Positive (yellow broth/no gas in the Durham tube)

D
Positive (yellow broth/gas in Durham tube)
Oxidase test: obligate aerobes
Produce cytochrome c oxidase (positive for the oxidase test)
Oxidase test: facultative anaerobes
Utilize different oxidases (negative for the oxidase test)
Carbohydrate fermentation
Determines if a microorganism can utilize a particular carbohydrate to do fermentation
Oxidase
Determines if a microorganism produces cytochrome c oxidase or not

A
Negative (bacteria doesn’t change color)

B
Positive (purple/pink color)
Why do you use a wooden stick to transfer bacteria to the paper during the oxidase test?
metals are great conductors of electrons (we don’t know if the loop or enzymes are doing the transferring)
avoid false positives
Catalase
determines if the microorganism produces catalase or not
distinguishes between Staphylococcus and Enterococcus bacteria

A
Negative (no bubbles)

B
Positive (bubbles)
Chemical reaction to catalase
2H2O2 (hydrogen peroxide) → 2H2O (water) + O2 (oxygen bubbles)
Nitrate reduction
Determines if the microorganism utilize (reduce) nitrate or not

A
Positive (tube that had nitrate A and nitrate B added)

B
Positive (tube that had nitrate A and B added -no color change - then zinc flakes were added)

C
Negative (tube that had nitrate A and B added - no color change - then zinc flakes were added)
Pathway for nitrate reduction
NO3 (nitrate) → NO2 (nitrite) → N2/NH3
Zinc flakes
Reduce nitrate to nitrite
What does SIM stand for?
Sulfur, Indole, Motility
What does IMViC stand for?
Indole, Methyl, Vogues Proskauer, Citrate (Simmons citrate)
Enterobacteriaceae
gram -
facultative anaerobe
enteric bacteria (intestinal)
Sulfur reactions
cysteine = food
thiosulfate = final electron acceptor

H2S
Produces black precipitate
Motility
Movement from the stab line

A
Positive (black precipitate through the whole tube)

B
Positive (black precipitate only along the stab line)

C
Negative (no black precipitate)
If a bacterium can use tryptophan, what is one of the products of this reaction?
Indole
Indole
Tryptophan = food

Methyl red
Mixed acid fermentation
Vogues Proskauer
Butanediol fermentation

A
Indole Positive

B
Indole Negative

A
Positive (after incubation the tube is cloudy away from the stab line)

B
Negative (after incubation and only growth long the stab line)
Mixed acid fermenter
lactic acid
succinic acid
acetic acid
formic acid
Butanediol fermenter
acetoin
acetyl-CoA
ethanol
lactic acid
formic acid
Which group of fermenters would result in a lower pH?
Mixed acid fermenter

A
MR Negative (2/3 amount of incubated broth mixed with MR reagents)

B
MR positive (2/3 of incubated broth mixed with MR reagent)

C
VP Negative (1/3 of incubated broth mixed with Barritt’s reagents)

D
VP Positive (1/3 of incubated broth mixed with Barrit’s reagents)
Citrate reaction
Citrate as sole carbon source


A
Negative (after incubation medium is a green color)

B
Positive (after incubation the medium turns a blue color)
Urea reaction

2 benefits of urea
allows urea to be used as nitrogen source
raises pH of environment

A
Negative (bacteria growth on the plate but no color change)
B
Positive (bacteria growth on the plate and a dark pink color on the plate
What are the 3 end products of fermentation?
acid
alcohol
gas
Why must a wooden stick be used to transfer bacteria onto the oxidase paper instead of a wire loop?
Metal can transfer electrons resulting in a false positive
What does the bacteria use nitrate for in the nitrate test?
Final electron acceptor
A fermentation tube detects if fermentation occurs. What is the function of the Durham tube?
Trap air bubbles
What oxygen radical does catalase destroy?
Hydrogen peroxide
What 2 groups of bacteria can be differentiated by using the oxidase test?
facultative anaerobe
obligate aerobe
If a bacteria is positive for Methyl Red in an MRVP tube, what type of fermenter is it?
Mixed acid fermenter
What are two metabolic pathways bacteria use to produce hydrogen sulfide, and how are the specific substrates utilized in each process?
break down cysteine for food
use thiosulfate as final electron acceptor

Is the bacteria in the picture positive or negative for indole production?
Negative

Is the bacteria in the picture positive or negative for indole production?
Positive

Is the bacteria in the picture positive or negative for motility?
Positive
What product(s) can be transported across the cell membrane if a bacteria contains DNase?
Nucleotides
What is casein?
Large white milk protein that provides nutrients and structure
You can see growth on your casein plate but there is no zone of clearing around the bacteria. What is the bacteria using to grow if it is not casein?
Other sugars and nutrients in the milk plate
What is the function of iodine in the starch test?
To see if starch is present around the bacteria
What product(s) can be transported across the cell membrane if a bacteria is able to break down starch?
glucose (monosaccharides)
maltose (disaccharides)